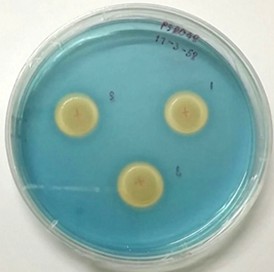
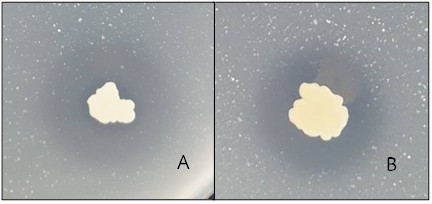

กระทรวงการอุดมศึกษา วิทยาศาสตร์ วิจัยและนวัตกรรม (อว.) โดย สถาบันวิจัยวิทยาศาสตร์และเทคโนโลยีแห่งประเทศไทย (วว.) นำผลการดำเนินงานขับเคลื่อน BCG Model ได้แก่ เทคโนโลยีและนวัตกรรมการจัดการขยะตาลเดี่ยวโมเดล (Tandiao Model) และปุ๋ยอินทรีย์เสริมแบคทีเรียละลายฟอสเฟตร่วมประชาสัมพันธ์การจัดแสดงนิทรรศการ APEC 2022 สัญจร “APEC พร้อม ไทยพร้อม” ซึ่งได้รับเกียรติจาก พลเอก ประวิตร วงษ์สุวรรณ รองนายกรัฐมนตรี เยี่ยมชมนิทรรศการ โดย นายอนุชา นาคาศัย รัฐมนตรีประจำสำนักนายกรัฐมนตรี และคณะผู้บริหาร ร่วมต้อนรับ เมื่อวันที่ 27 กันยายน 2565 ณ บริเวณโถงกลาง ตึกสันติไมตรี ทำเนียบรัฐบาล



นิทรรศการ APEC 2022 สัญจร “APEC พร้อม ไทยพร้อม” ดำเนินงานภายใต้โครงการประชาสัมพันธ์การเป็นเจ้าภาพเอเปคของไทย ปี 2565 เพื่อประชาสัมพันธ์และสร้างการรับรู้การเป็นเจ้าภาพจัดการประชุมกรอบความร่วมมือทางเศรษฐกิจในภูมิภาคเอเชีย-แปซิฟิก (Asia Pacific Economic Cooperation: APEC) ในปี พ.ศ. 2565 ของไทย และผลงานสำคัญของรัฐบาล โดยการประชุมสุดยอดผู้นำเอเปคจะมีสมาชิก 21 เขตเศรษฐกิจ เข้าร่วมการประชุม ซึ่งกำหนดจัดขึ้นระหว่างวันที่ 18-19 พฤศจิกายน 2565 ภายใต้หัวข้อหลักคือ OPEN. CONNECT. BALANCE. หรือ “เปิดกว้าง สร้างสัมพันธ์ เชื่อมโยงกัน สู่สมดุล” เพื่อเปิดกว้างสู่ทุกโอกาสด้านการค้าและการลงทุน เชื่อมโยงในทุกมิติ เพื่อฟื้นฟูการเดินทางระหว่างกันที่สะดวกและปลอดภัย และส่งเสริมการเจริญเติบโต ที่เน้นสร้างสมดุลในทุกด้าน ผ่านการดำเนินธุรกิจอย่างมีความรับผิดชอบ โดยคำนึงถึงสิ่งแวดล้อม รวมทั้งการสร้างความมั่นคงทางอาหารและการเกษตร เพื่อความเป็นอยู่ที่ดีของประชาชน ทั้งนี้ได้มีการปล่อยคาราวานรถนิทรรศการ APEC 2022 สัญจร ออกไปสู่ภูมิภาค ในวันที่ 28 กันยายน 2565 ณ กรมประชาสัมพันธ์ และจะมีการเปิดตัว ณ สำนักประชาสัมพันธ์เขต ทั้ง 8 เขตพร้อม ๆ กัน ในวันที่ 30 กันยายน 2565 เพื่อสร้างการรับรู้แก่กลุ่มเป้าหมาย ครอบคลุม 77 จังหวัดทั่วประเทศไทย


ผลงานขับเคลื่อน BCG Model ของ วว. ที่นำมาร่วมจัดแสดงเพื่อประชาสัมพันธ์กิจกรรมดังกล่าว มีรายละเอียด ดังนี้

1.เทคโนโลยีและนวัตกรรมการจัดการขยะตาลเดี่ยวโมเดล (Tandiao Model) วว. โดยศูนย์เชี่ยวชาญนวัตกรรมพลังงานสะอาดและสิ่งแวดล้อม พัฒนาเป็นโครงการนำร่อง โดยร่วมดำเนินการกับ องค์การบริหารส่วนตำบลตาลเดี่ยว ชุมชนในพื้นที่ และจังหวัดสระบุรี เพื่อแก้ไขและลดปัญหาขยะชุมชน รวมถึงขยะพลาสติกที่เหลือทิ้ง มุ่งเน้นให้เป็นโครงการต้นแบบเพื่อนำผลงานวิจัยด้านวิทยาศาสตร์ เทคโนโลยี และนวัตกรรม (วทน.) มาใช้ให้เกิดประโยชน์ต่อการจัดการขยะชุมชน โดยนำกลับมาใช้ประโยชน์ใหม่และเพิ่มมูลค่าขยะอย่างมีประสิทธิภาพตามหลักเศรษฐกิจหมุนเวียน (Circular Economy) ด้วยเทคโนโลยีและนวัตกรรมที่เป็นมิตรต่อสิ่งแวดล้อม บริหารจัดการแบบชุมชนมีส่วนร่วม สามารถสร้างรายได้และความยั่งยืนกลับคืนสู่ชุมชน มุ่งเน้นการเปลี่ยนขยะเพื่อสร้างรายได้ (Waste-to-Wealth) ประกอบด้วย เทคโนโลยีการคัดแยกและแปรรูปขยะพลาสติกเป็นวัตถุดิบรอบสองที่มีคุณภาพ การผลิตสารปรับปรุงดิน และผลิตภัณฑ์ชุมชนจากของเหลือทิ้ง เช่น ถ่านหอม 3 in 1 และการเปลี่ยนขยะเป็นพลังงาน (Waste-to-Energy) ประกอบด้วย การผลิตเชื้อเพลิงขยะ (RDF5) เพื่อทดแทนถ่านหินและการผลิตพลังงานทดแทนชีวภาพจากน้ำชะขยะพร้อมระบบบำบัดน้ำเสีย สอบถามรายละเอียดเพิ่มเติมติดต่อ ดร.เรวดี อนุวัฒนา นักวิจัยอาวุโส ศูนย์เชี่ยวชาญนวัตกรรมพลังงานสะอาดและสิ่งแวดล้อม โทร. 0 2577 9000

2. ปุ๋ยอินทรีย์เสริมแบคทีเรียละลายฟอสเฟต (Phosphate solubilizing bacteria: PSB) วว. โดย ศูนย์เชี่ยวชาญนวัตกรรมเกษตรสร้างสรรค์ วิจัยและพัฒนาสำเร็จ โดยเตรียมจากแบคทีเรียชนิด Bacillus pumilus TISTR 1476 และ Bacillus amyloliquefaciens TISTR 1475 บนสูตรวัสดุอินทรีย์ที่ผ่านการย่อยสลายสมบูรณ์ ที่มีปริมาณประมาณ 108 CFU/g จากการทดสอบในห้องปฏิบัติการพบว่า แบคทีเรียทั้ง 2 ชนิด มีความสามารถละลายฟอสเฟตในดินได้เพิ่มขึ้นประมาณ 55% จาก 30.7 mg/kg เป็น 68.8-78.1 และ 73.9-75.9 mg/kg ตามลำดับ และแบคทีเรียทั้ง 2 ชนิด ส่งผลเชิงบวกต่อการเจริญเติบโตของพืชทดสอบ สำหรับการนำไปใช้ในการผลิตอ้อยในสภาพแปลงปลูกจังหวัดกาญจนบุรี ที่ดินมีสภาพเป็นด่าง (pH ประมาณ 8) B. pumilus ซึ่งจะมีความเหมาะสมต่อการนำไปใช้มากกว่า เนื่องจากสามารถเจริญเติบโตและคงอยู่ในดินเนื้อปูนของกาญจนบุรีได้ยาวนานกว่าและละลายฟอสเฟตออกมาได้ในระยะเวลาที่นานกว่า การนำผลิตภัณฑ์ไปใช้มีดังนี้ ผสมปุ๋ยอินทรีย์เสริม PSB อัตราส่วน 500 กรัม ต่อปุ๋ยอินทรีย์หรือปุ๋ยอินทรีย์เคมีสูตรต่ำอัตรา 50 กิโลกรัม เคล้าให้เข้ากันแล้วหว่านตามปกติ สอบถามรายละเอียดเพิ่มเติมติดต่อ ดร.กนกพร อัมพราย นักวิจัยอาวุโส ศูนย์เชี่ยวชาญนวัตกรรมเกษตรสร้างสรรค์ วว. โทร. 0 2577 9000

นำเสนอข่าวโดย
กองประชาสัมพันธ์ สำนักสื่อสารองค์กร วว.
โทร. 0 2577 9360
E-mail : pr@tistr.or.th
Line@TISTR
IG : tistr_ig
Views: 115
